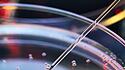

Kürzlich sorgten Forscher aus Großbritannien und Israel weltweit für Schlagzeilen. Wie ein Lauffeuer verbreitete sich die Nachricht, ihnen sei es gelungen, embryoartige Gebilde im Labor herzustellen. Nicht, wie üblich, mittels künstlicher Befruchtung, sondern durch Reprogrammierung humaner Stammzellen. Selbst in den renommierten Wissenschaftsmagazinen „Nature“ und „Science“ war von der Erschaffung „synthetischer Embryonen“ die Rede. Nun versucht die „Internationale Gesellschaft für Stammzellforschung“ (ISSCR), den Begriff wieder einzusammeln. Anlass zur Beruhigung ist das nicht.
Nach Ansicht des Medizinrechtlers Nils Hoppe von der Leibniz-Universität Hannover ist es nur eine Frage der Zeit, bis die neuartigen Embryomodelle sich, zumindest über weite Stadien hinweg, nicht mehr von einem klassischen menschlichen Embryo unterscheiden ließen. „Falls wir an den Punkt kommen, so etwas implantieren zu können, sodass sich daraus ein ganz normaler Mensch entwickelt“, werde „die ganze moralische und juristische Diskussion noch einmal ganz neu geführt werden“ müssen. „Denn dann könnte man mit dieser Methode faktisch Menschen klonen“, sagte Hoppe im Interview mit dem „Laborjournal“.
Forscher: „Ich bin nicht gegen das Klonen, ich bin gegen die Heuchelei“
Zuvor hatte der Münsteraner Embryologe Michele Bioani vom Max-Planck-Institut für molekulare Biomedizin demselben Medium gesagt: „Ich finde es daher ein bisschen heuchlerisch, wenn einige Leute mit diesen Begriffen spielen. Für mich sind die Embryoiden nichts anderes als Klonen im Verborgenen. Die ethische Gemeinschaft hat vor zwanzig Jahren gegen das Klonen protestiert, und jetzt wird uns das Klonen wieder auf dem Teller serviert, und niemand sagt etwas. Um es klarzustellen: Ich bin nicht gegen das Klonen, ich bin gegen die Heuchelei. Ich verstehe nicht, wie man die Transplantation des somatischen Zellkerns in die Eizelle abweisen, aber mit dem Bau von Embryo-ähnlichen Strukturen aus Zelllinien einverstanden sein kann.“
Mit der Erschaffung der sogenannten „synthetischen Embryonen“ beschäftigt sich auch die aktuelle Ausgabe der „Tagespost“. Unter der Überschrift „Der letzte Frevel“ analysiert der Wissenschaftsjournalist Stefan Rehder die Erklärung der ISSCR für das Ressort „Glaube & Wissen“. Dabei artikuliert der Bioethik-Korrespondent der „Tagespost“ Zweifel an der Darstellung, wonach der Zweck der Experimente ausschließlich in dem Bemühen um ein besseres Verständnis der Ursachen von Frühaborten bestehe, und zeigt auf, worum es stattdessen gehen dürfte und erklärt, warum dies viel wahrscheinlicher sei. DT/reh
Lesen Sie den ausführlichen Beitrag über die Erschaffung der sogenannten „synthetischen Embryonen“ in der kommenden Ausgabe der "Tagespost".